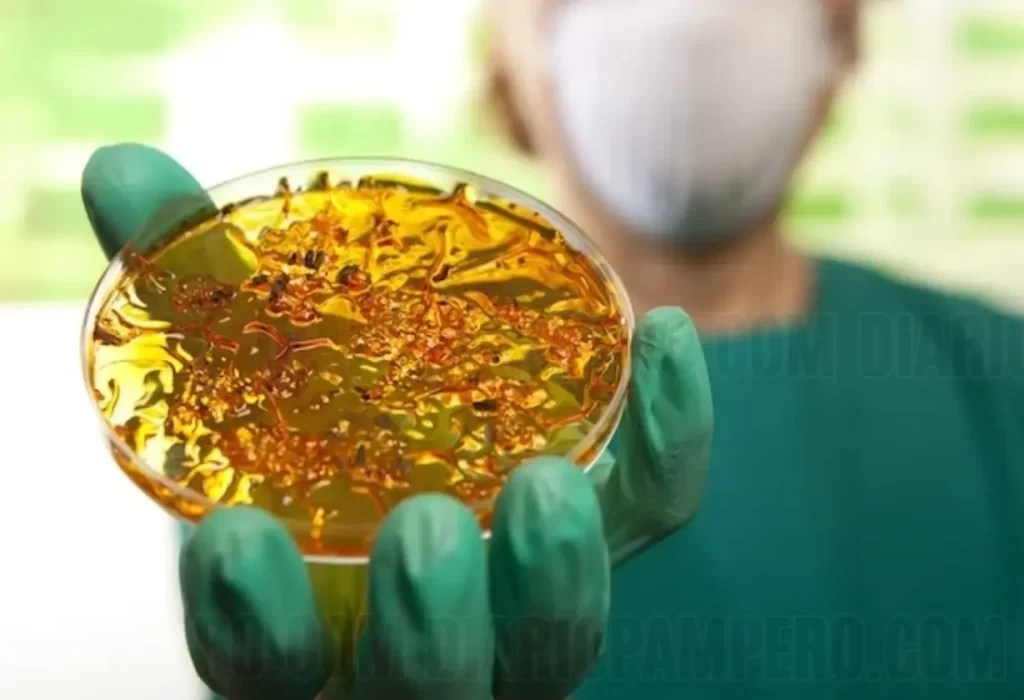

Brasil confirma primer caso autóctono de cólera en dos décadas
Las autoridades sanitarias de Brasil confirmaron un caso autóctono de cólera en el país, el primero que se detecta de esta enfermedad en los últimos 20 años. La alerta se encendió en la ciudad de Salvador, capital del estado de Bahía, donde un hombre de 60 años fue diagnosticado con la bacteria Vibrio cholerae en marzo pasado.
Según informó el Ministerio de Salud brasileño, el paciente no tenía antecedentes de viajes a países con casos confirmados de cólera ni había estado en contacto con personas contagiadas, lo que indicaría que se trata de un caso de transmisión local.
Tras un estudio epidemiológico, las autoridades sostienen que se trataría de un caso aislado, ya que no se identificaron otros registros luego de rastrear los contactos estrechos del paciente en Salvador. Asimismo, aseguraron que desde el 10 de abril la persona afectada ya no representa un riesgo de contagio.
La cólera es una enfermedad infecciosa intestinal aguda que se propaga por la ingestión de agua o alimentos contaminados con materia fecal. Los últimos casos autóctonos en Brasil se habían registrado entre 2004 y 2005 en el estado de Pernambuco. Desde 2006, solo se reportaban casos importados de países como Angola, República Dominicana, Mozambique e India.
Esta confirmación de un nuevo caso de cólera de origen local en suelo brasileño encendió las alarmas sanitarias, en un contexto en el que, según la Organización Mundial de la Salud, 31 países han reportado casos o brotes de la enfermedad en lo que va del año, siendo África la región más afectada con 18 naciones impactadas.
En las Américas, hasta el momento solo se han notificado casos en Haití y República Dominicana, por lo que las autoridades brasileñas deberán extremar los controles epidemiológicos para evitar la propagación de un brote de mayores dimensiones en el país más poblado de la región.
DESCARGAR APLICACIÓN DE LA RADIO EN VIVO
 Gracias por estar en Diario Pampero, visítanos para estar informado!
Gracias por estar en Diario Pampero, visítanos para estar informado!
Si necesitas parte de este contenido, no olvides citar la fuente de información. Respetamos a quienes producen contenidos, artículos, fotos, videos. Compartimos información de La Pampa para los pampeanos y te informamos sobre toda la actualidad nacional e internacional destacada.
Si compartes nuestro contenido, nos ayudas a crecer como medio de comunicación!
















